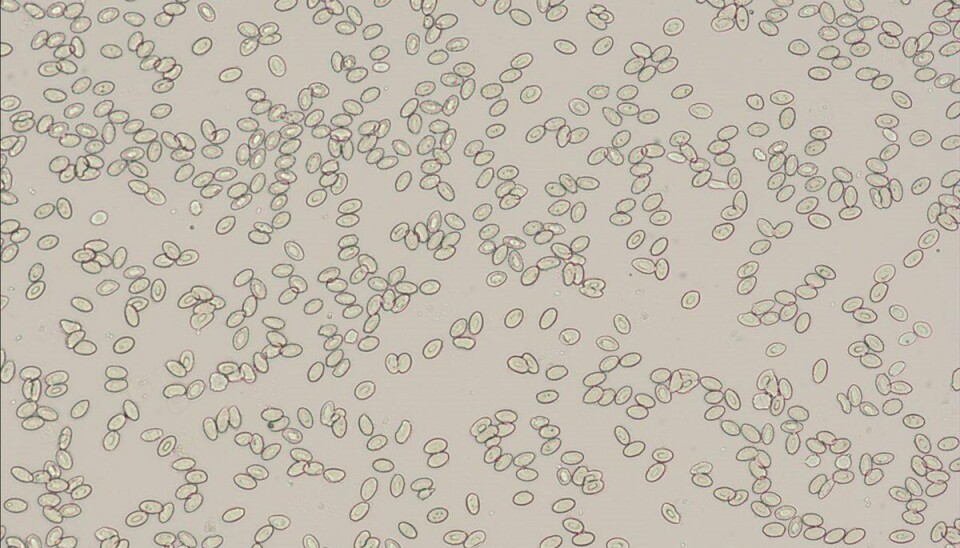

Vil finne ut hvorfor triploid laks har dårligere velferd
Avvikende genetisk arv kan gi oss svar på hvorfor steril triploid laks sliter.
Nå har forskerne ved Havforskningsinstituttet utviklet en ny metode for å forstå hvorfor triploid laks har dårligere velferd enn annen oppdrettslaks.
Fordelen med å oppdrette triploid laks er at de er sterile, i tillegg vokser de bedre enn ‘vanlig’ diploid oppdrettslaks.
– Dersom de rømmer kan de ikke pare seg med villaksen. Det er en fordel for å redusere genetisk påvirkning på villaks, sier forsker Aurélien Delaval.
Problemet er at slik fisk ofte har dårlig helse sammenlignet med diploid fisk, som ikke er steril.
– Triploid laks er mer utsatt for skjelett- og hjertefeil, grå stær, infeksjonssykdommer og hudsår, sier Delaval.
Tidligere er det gjort forsøk på kommersiell produksjon av triploid laks i Norge, men problemene med velferd gjorde at det ikke produseres slik fisk nå. Andre land som prøver å få til produksjon av slik fisk er Australia og Canada.
Triploid laks har større blodceller
Triploid fisk lages ved at eggene utsettes for trykk.
For å bekrefte at laksen får et ekstra sett med kromosomer slik at den blir triploid, tar forskerne vanligvis blodprøver fra fisken og ser på blodcellene.
– Hos triploid laks er blodcellene større, fordi de har flere kromosomer og dermed mer DNA som tar opp mer plass. Da kan vi se forskjellen mellom triploid og diploid laks, forklarer prosjektleder Alison Harvey.
Ny genetisk metode avdekker avvikende arv
Til tross for at forskjellen på blodcellene viser at fisken har «noe ekstra», mistenkte forskerne at svaret på hvorfor noen av de triploide fiskene sliter med dårlig helse lå i genetikken.
Dermed utviklet de en ny metode for mer presis identifisering av hvilken genetisk arv de triploide fiskene fikk med seg gjennom trykkbehandlingen.

– Vi gikk over til å bruke genetiske markører for å spore kromosom-arven fra foreldre til avkom, forklarer Harvey.
Gjennom denne metoden oppdaget forskerne at noen laks hadde avvikende arvemønstre.
– Noen av dem var verken triploide eller diploide, men noe imellom, med to sett kromosomer fra noen gener og tre fra andre. I noen tilfeller arvet de også kun gener fra faren, ikke fra mora, sier Harvey.
Det må undersøkes nærmere om disse var sterile eller ikke – og om det er dette som gjør at en del av fisken som har fått slik behandling, har dårligere helse.
Forskeren har allerede sett på hvorfor dette skjedde.
– Vi har sjekket om det er måten vi lager triploid laks på som gjør at en del av fiskene har fått avvikende arv, sier Delaval.
Trykkbehandling kan være årsaken
For å finne ut av dette, ble egg fra forskjellige laksefamilier utsatt for fem ulike trykkbehandlinger.
Slik gjorde vi det:
- En gruppe fisk ble ikke utsatt for trykk og ble derfor produsert som vanlige diploide, ikke-sterile fisk.
- En annen gruppe ble utsatt for høyt trykk for å lage triploid laks.
- De tre siste gruppene ble utsatt for en gradient med lavere trykk for å etterligne mislykkede trykkbehandlinger.

– Vi oppdaget at avvikende arv skjedde hos en liten andel av eggene i alle gruppene, inkludert de som ikke var utsatt for noe trykkbehandling, forklarer Delaval, og fortsetter:
– Dette viser at avvikende arv er noe som skjer naturlig, akkurat som hos andre arter, inkludert hos mennesker.
Men avvikende arv ble oppdaget i mye større grad i de tre gruppene som hadde hatt «mislykkede» trykkbehandlinger, og dødeligheten blant eggene var høyere.
Det tyder på at mislykkede trykkbehandlinger kan være årsaken til økt forekomst av avvikende arvemønstre og økt dødelighet.
Må undersøkes videre
Nå gjenstår det å undersøke om noen av disse eggene overlever og utvikler seg til fisk med genetiske syndromer.
– Dersom vi oppdager fisk som har utviklet deformiteter med redusert vekst og økt sykdomssårbarhet, som følge av trykkbehandlingen, vil de bli undersøkt videre etter hvert som fisken vokser, sier Delaval.
Om prosjektet
Prosjektet er finansiert av Norges forskningsråd (NFR). Målet er å undersøke de genetiske årsakene til velferdsutfordringer hos triploid laks, inkludert om trykkbehandlingen kan være en av årsakene.
Referanse
Delaval, A., Glover, K.A., Solberg, M.F. et al. Chromosomal aberrations and early mortality in a non-mammalian vertebrate: example from pressure-induced triploid Atlantic salmon.